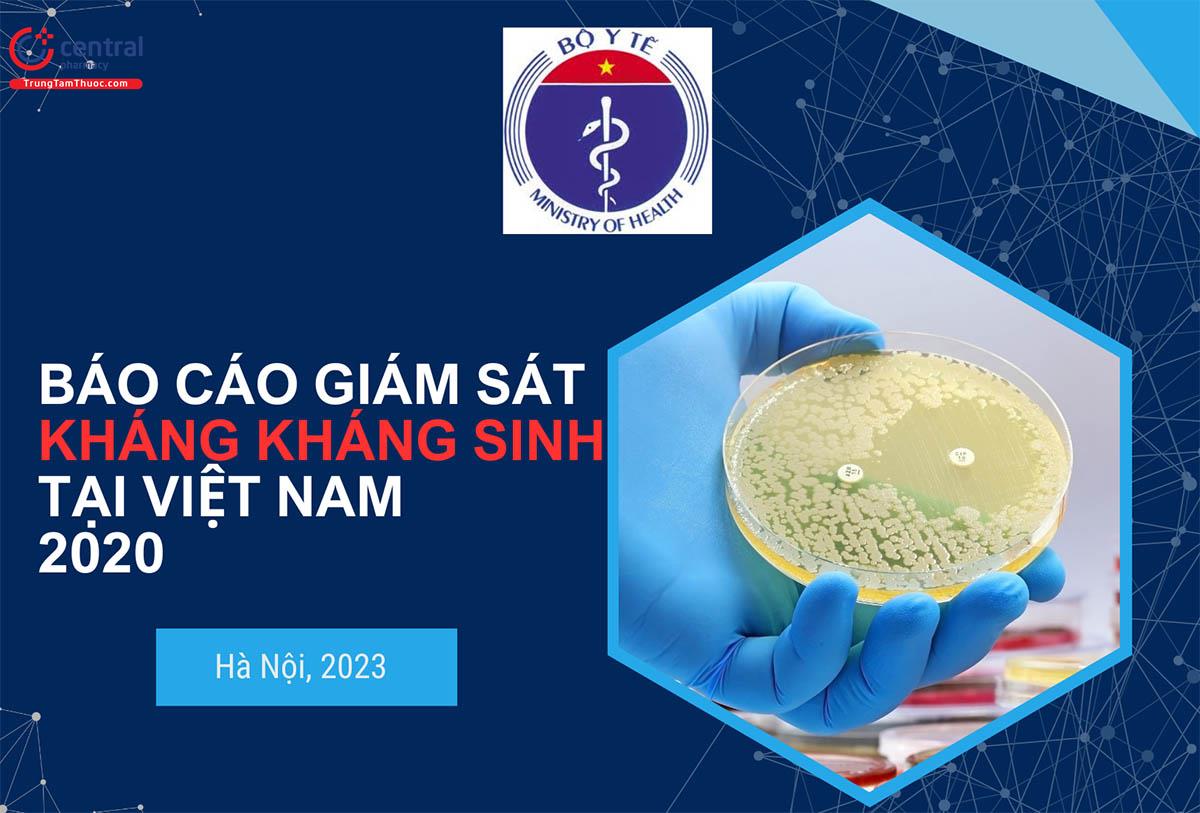

Hiện tại Việt Nam vẫn còn diễn ra việc sử dụng kháng sinh chưa hợp lý khiến tình trạng kháng kháng sinh ngày càng gia tăng, tạo điều kiện cho vi sinh vật có khả năng chống lại thuốc và có thể trở nên “đa kháng” hoặc “siêu kháng thuốc”…Vì vậy, cần tuyên truyền và hướng dẫn cho Sinh viên Khối học Dược hiểu rõ về phòng chống Kháng thuốc Kháng sinh ngay từ trên ghế trường học.

Khi loại thuốc kháng sinh đầu tiên được đưa vào điều trị, chúng đã được chào đón như là “thần dược”, là phép lạ của y học hiện đại. Thế nhưng, kho “vũ khí” này hiện đang bị mất dần công hiệu. Sự kháng kháng sinh của các loại vi khuẩn đang là thách thức lớn trong việc điều trị các bệnh do vi khuẩn gây ra. Vậy cần có những giải pháp nào để hạn chế và phòng tránh sự kháng thuốc này ?
Kháng thuốc là mối đe dọa sức khỏe và sự phát triển trên toàn cầu, đòi hỏi hành động đa ngành khẩn cấp để đạt được các mục tiêu phát triển bền vững. Tổ chức Y tế thế giới đã tuyên bố kháng thuốc là một trong 10 mối đe dọa hàng đầu sức khỏe công cộng toàn cầu mà nhân loại phải đối mặt. Việc sử dụng sai và lạm dụng thuốc là nguyên nhân chính dẫn đến sự phát triển của vi sinh vật kháng thuốc. Hiện nay, kháng thuốc vẫn đang là mối lo ngại ở Việt Nam bất chấp những tiến bộ khoa học đã đạt được trong 10 năm qua. Các nghiên cứu gần đây cho thấy từ xu hướng kháng kháng sinh ngày càng tăng trong thập kỷ qua. Nhiều thách thức vẫn còn tồn tại, bao gồm năng lực hạn chế của các phòng xét nghiệm trong việc giám sát và phân tích dữ liệu, kê đơn thuốc kháng sinh không phù hợp và thiếu việc thực thi cũng như giám sát các quy định về bán thuốc kháng sinh. Chiến lược Quốc gia về phòng, chống kháng thuốc giai đoạn 2023-2030, tầm nhìn đến năm 2045 đã được Thủ tướng Chính phủ phê duyệt tại Quyết định 1121/QĐ-TTg ngày 25/09/2023. Để đạt được mục tiêu Chiến lược trong giai đoạn tới, đòi hỏi sự nỗ lực và cam kết của tất cả các bộ, ngành, các cấp từ trung ương đến địa phương cùng vào cuộc để ngăn chặn tình trạng kháng thuốc.
Cần cung cấp thông tin đầy đủ về thuốc KS cho bác sĩ kê đơn để nắm vững tác dụng dược lý, có chế tác động của từng loại thuốc Kháng sinh đối với vi khuẩn. Từ đó mới có sự kê đơn hợp lý, tránh lạm dụng thuốc KS từ chính các Thầy thuốc.
Làm chậm sự tiến triển kháng thuốc, ngăn chặn, kiểm soát sự lây lan của các vi sinh vật kháng thuốc, đồng thời đảm bảo sự sẵn có, liên tục cũng như sử dụng thuốc kháng sinh hợp lý để điều trị hiệu quả các bệnh truyền nhiễm ở người, động vật, góp phần bảo vệ, chăm sóc, nâng cao sức khỏe con người, động vật, bảo vệ môi trường, phát triển kinh tế, xã hội của đất nước là nhiệm vụ cấp bách hiện nay của cả hệ thống chính trị ở nước ta. Chiến lược quốc gia về phòng, chống kháng thuốc tại Việt Nam thể hiện nỗ lực của Chính phủ Việt Nam, phối hợp với Tổ chức Y tế thế giới và các đối tác quốc tế khác nhằm chống lại sự gia tăng của tình trạng kháng thuốc. Chiến lược đưa ra các giải pháp nhằm tăng cường giám sát, thúc đẩy sử dụng kháng sinh có trách nhiệm. Trên cơ sở mục tiêu chung nêu trên, chiến lược đưa ta 4 mục tiêu cụ thể gồm: Nâng cao nhận thức của các cấp chính quyền địa phương, hiểu biết của nhân viên y tế, thú y và người dân về phòng, chống kháng thuốc. Tiếp đó là củng cố hệ thống giám sát kháng thuốc để cảnh báo kịp thời về sự xuất hiện, lan truyền, mức độ, xu hướng kháng thuốc của các vi sinh vật; giảm sự lan truyền của vi sinh vật, bệnh truyền nhiễm, sử dụng thuốc kháng vi sinh vật ở người, động vật hợp lý, an toàn và có trách nhiệm.
Để hạn chế tình trạng lạm dụng thuốc KS và dùng KS bao vây như hiện nay, các Dược sĩ làm việc tại Khoa dược BV cần cung cấp thông tin cho bác sĩ, điều dưỡng và bệnh nhân về việc dùng KS đúng liều và đúng thuốc. Các BV cần phải làm tốt công tác dược lâm sàng, bình bệnh án và thông tin thuốc. Nếu làm tốt các công tác này sẽ hạn chế được rất nhiều tình trạng sử dụng KS không đúng quy định trong BV. Và việc thay đổi hành vi và thói quen sử dụng thuốc KS không đúng quy định, cần bắt đầu từ chính thầy thuốc. Bên cạnh đó các Khoa dược BV cần được trạng bị hệ thống bảo quản thuốc đạt chuẩn và có kho KS riêng. Vì KS nếu bảo quản không tốt sẽ bị giảm tác dụng cũng là nguyên nhân gây nên tình trạng kháng thuốc.
ThS – DS Lê Quốc Thịnh – Khoa Dược – HMC Mỹ Đình
